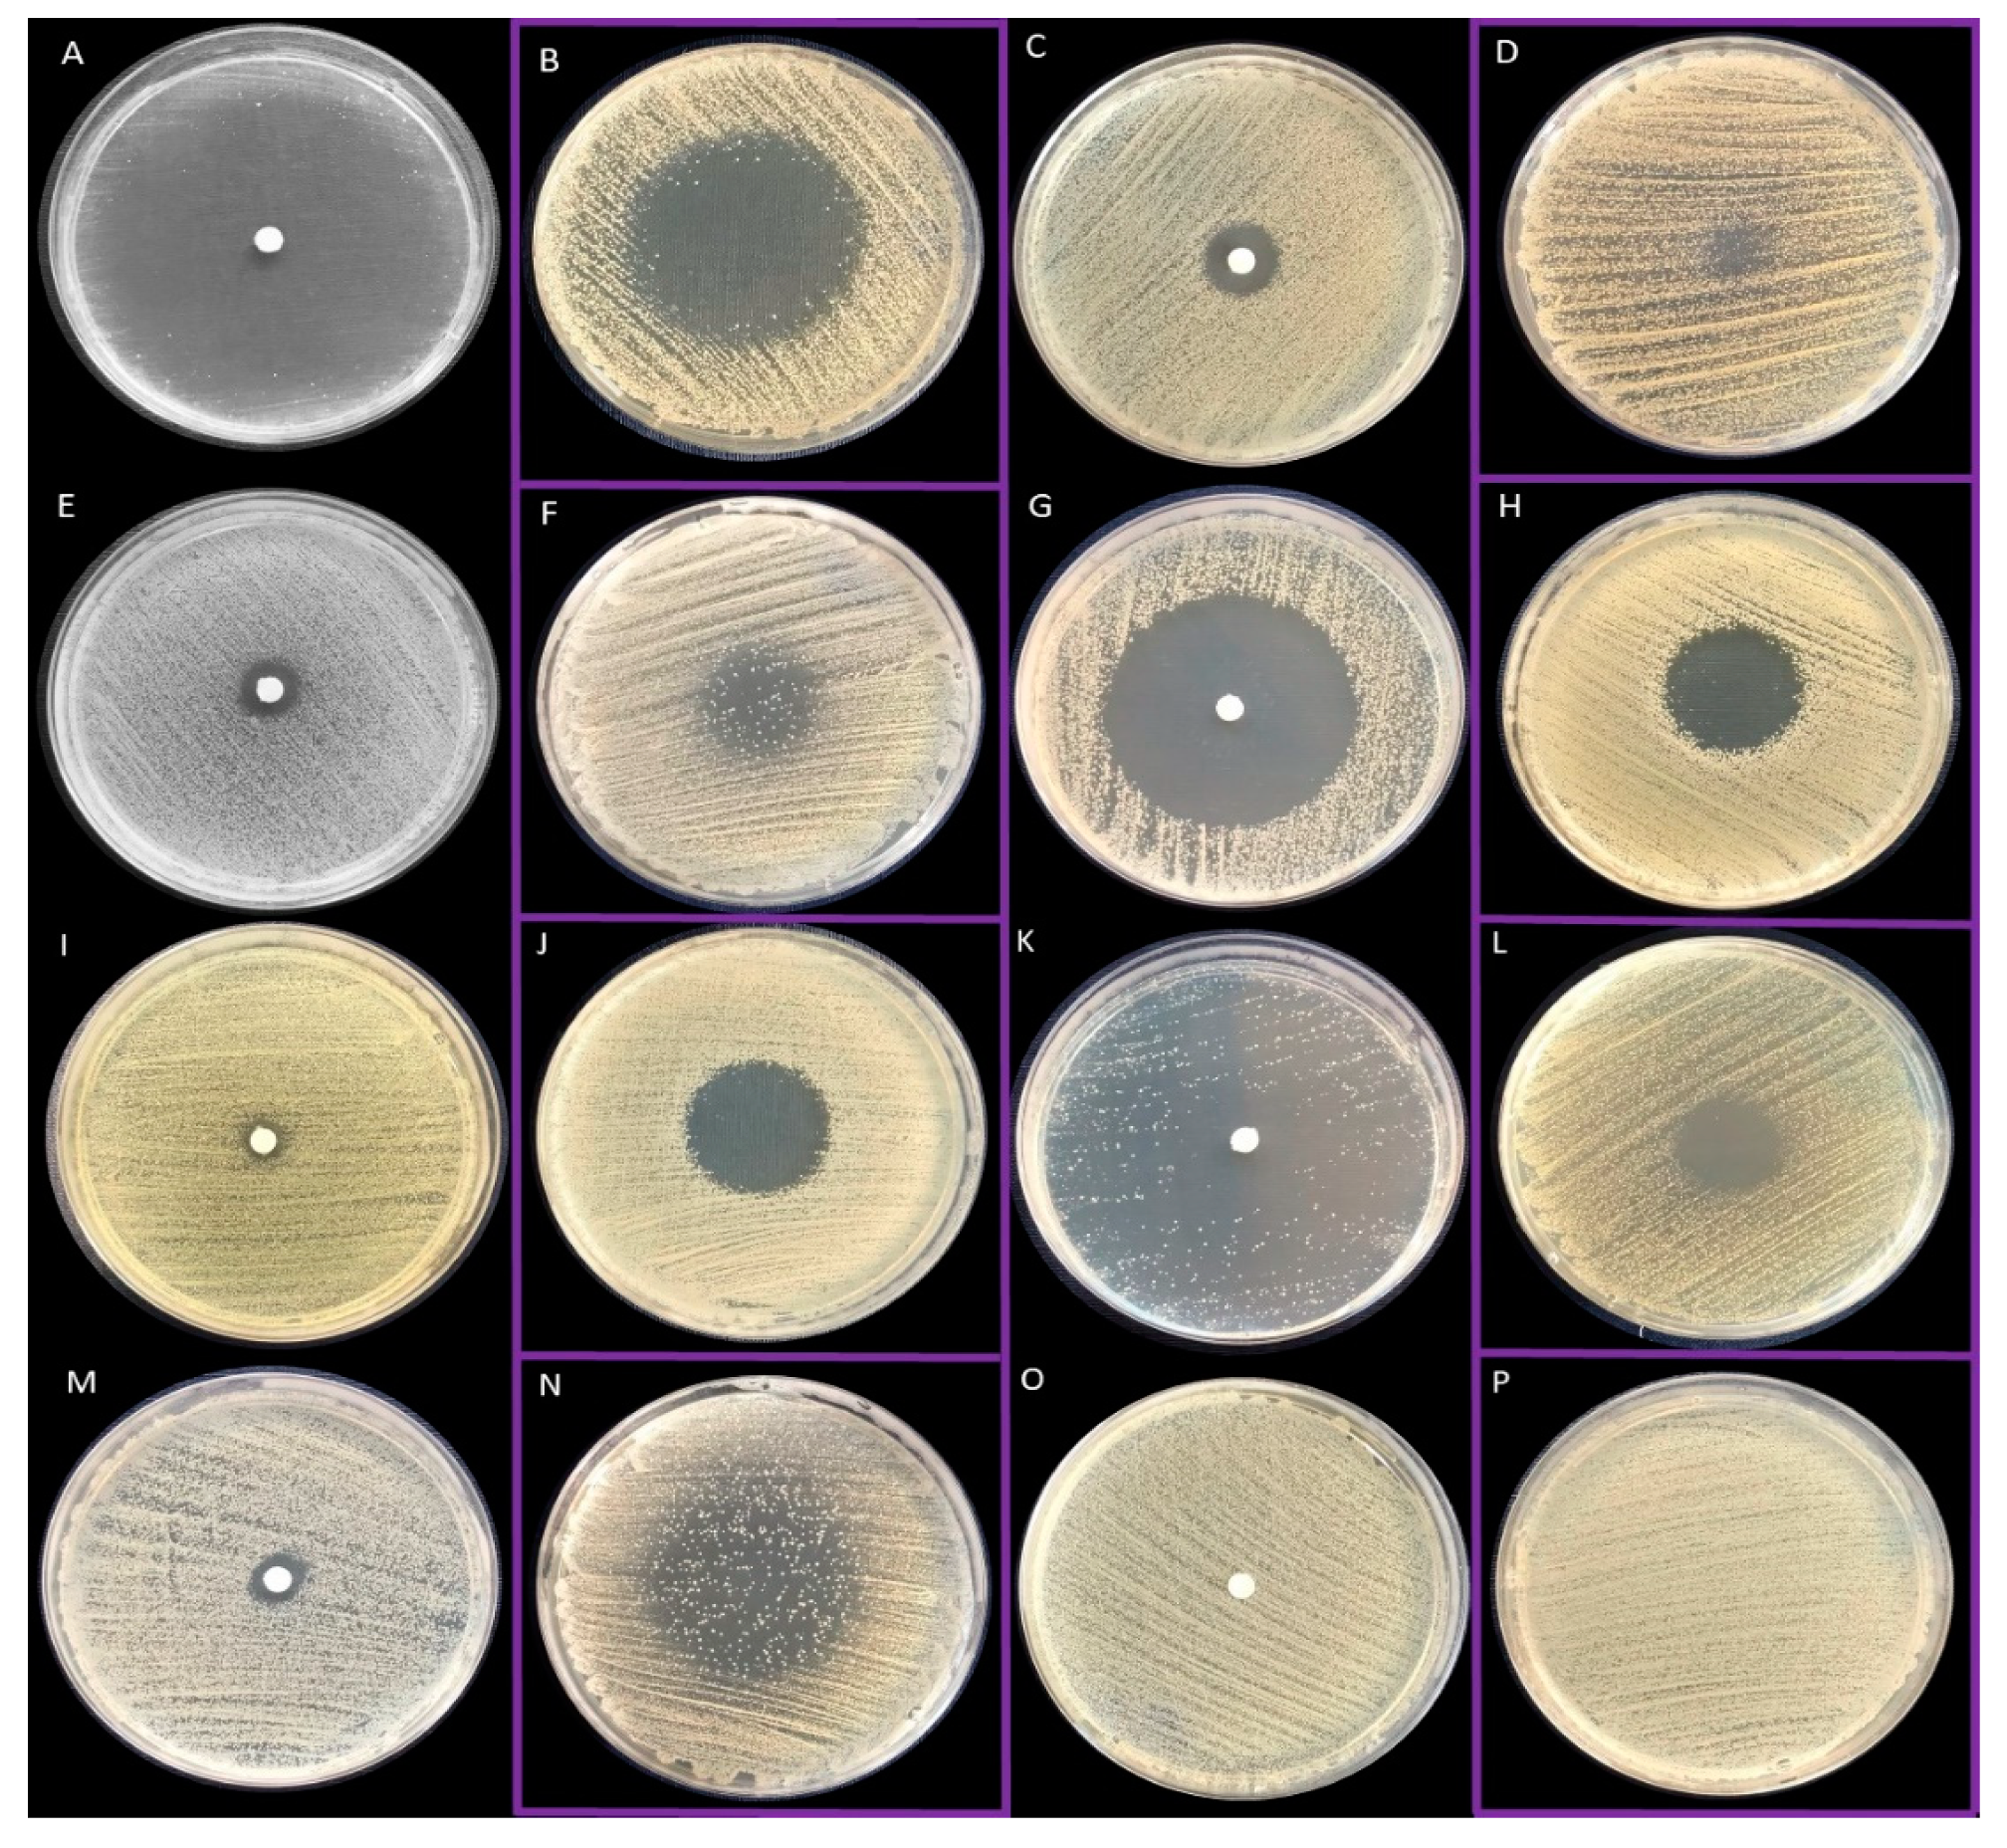
Pathogens 10 01207 g002 Pathogens 10 01207 g002

The Antimicrobial and Antibiofilm In Vitro Activity of Liquid and Vapour Phases of Selected Essential Oils against Staphylococcus aureus
Abstract
1. Introduction
2. Results
2.1. Assessment of EOs Compositions Using Gas Chromatography Mass Spectrometry
2.2. Assessment of Biofilm Biomass Level Using Crystal Violet Assay and Biofilm Metabolic Activity Level Using Tetrazolium Chloride Staining
2.3. Antimicrobial Activity of All EOs Using Disc Diffusion Method and Inverted Petri Dish Method
2.4. Evaluation of the Minimal Inhibitory Concentration (MIC) of Liquid Fractions of All EOs Emulsions in Tween 20 Using Serial Microdilution Method
2.5. Evaluation of the Minimal Biofilm Eradication Concentration (MBEC) and the Minimal Bactericidal Concentration for Biofilm (MBC-B) of Liquid Fractions of All EOs Emulsions in Tween 20
2.6. Evaluation of Antibiofilm Activity of All Non-Emulsified EOs’ Liquid Fractions Measured with Modified Antibiofilm Dressing’s Activity Measurement Assay
2.7. Evaluation of Antibiofilm Activity of All Non-Emulsified Eos’ Volatile Fractions Measured with AntiBioVol Assay
2.8. Visualisation of Impact of T-EO Emulsions’ Liquid Fractions on Staphylococcal Biofilm Using LIVE/DEAD Staining and Epifluorescence Microscopy
2.9. Three Dimensional Visualization of Alterations of Staphylococcal Biofilm Exposed to Volatile Fractions of R-EO
2.10. Size of Emulsified EOs Droplets
3. Discussion
4. Materials and Methods
4.1. Microorganisms and Culture Conditions
4.2. Essential Oils
- Thyme oil (T-EO, obtained from Thymus vulgaris L. herb) was purchased from Etja, Elblag, Poland;
- Tea tree oil (TT-EO, obtained from Melaleuca alternifolia Cheel. leaves) was purchased from Pharmatech, Zukowo, Poland;
- Basil oil (B-EO, obtained from Ocimum basilicum L. leaves and flowers) was purchased from Nanga, Zlotow, Poland;
- Rosemary oil (R-EO, obtained from Rosmarinus officinalis L. flowering shoots) was purchased from Nanga, Zlotow, Poland;
- Eucalyptus oil (E-EO, obtained from Eucalyptus globulus Labill. leaves and twigs) was purchased from Pharmatech, Zukowo, Poland;
- Lavender oil (L-EO, obtained from Lavandula angustifolia Mill. flowering herb) was purchased from Kej, Cirkowice, Poland;
- Menthol mint oil (M-EO, obtained from Mentha arvensis L. leaves) was purchased from Optima Natura, Grodki, Poland.
4.3. GC-MS (Gas Chromatography Mass Spectrometry) Analysis of the Tested EOs Composition
4.3.1. Essential Oil Preparation
4.3.2. GC-MS Analysis
4.4. Assessment of Biofilm Biomass Level Using Crystal Violet Assay
4.5. Assessment of Biofilm Activity Level Using TTC Staining
4.6. Evaluation of the Antimicrobial Activity of All EOs Using Disc Diffusion Method and Inverted Petri Dish Method
4.7. Evaluation of Minimal Inhibitory and Minimal Biofilm Eradication Concentrations of Liquid Fractions of EOs Emulsions
4.8. Evaluation of Antibiofilm Activity of All Non-Emulsified EOs’ Liquid Fractions Using Modified A.D.A.M. (Antibiofilm Dressing’s Activity Measurement) Assay
4.8.1. Biofilm Plugs Preparation
4.8.2. Treatment with EOs
4.8.3. Viability Measurement
4.9. Evaluation of Antibiofilm Activity of All Non-Emulsified EOs’ Volatile Fractions Measured with AntiBioVol Assay (Antibiofilm Activity of Volatile Compounds)
4.9.1. Biofilm Plugs Preparation
4.9.2. Treatment with EOs
4.9.3. Viability Measurement
4.10. Fluorescence Microscopy of Biofilms Visualised with Use of LIVE/DEAD Staining
4.11. Analysis on the Size of EOs Emulsion Droplets
Supplementary Materials
Author Contributions
Funding
Institutional Review Board Statement
Informed Consent Statement
Data Availability Statement
Conflicts of Interest
References
- Hall, C.W.; Mah, T.F. Molecular Mechanisms of Biofilm-Based Antibiotic Resistance and Tolerance in Pathogenic Bacteria. FEMS Microbiol. Rev. 2017, 41, 276–301. [Google Scholar] [CrossRef]
- dos Santos Ramos, M.A.; da Silva, P.B.; Spósito, L.; de Toledo, L.G.; vidal Bonifácio, B.; Rodero, C.F.; dos Santos, K.C.; Chorilli, M.; Bauab, T.M. Nanotechnology-Based Drug Delivery Systems for Control of Microbial Biofilms: A Review. Int. J. Nanomed. 2018, 13, 1179–1213. [Google Scholar] [CrossRef]
- Schultz, G.; Bjarnsholt, T.; James, G.A.; Leaper, D.J.; McBain, A.J.; Malone, M.; Stoodley, P.; Swanson, T.; Tachi, M.; Wolcott, R.D. Consensus Guidelines for the Identification and Treatment of Biofilms in Chronic Nonhealing Wounds. Wound Repair Regen. 2017, 25, 744–757. [Google Scholar] [CrossRef]
- Jamal, M.; Ahmad, W.; Andleeb, S.; Jalil, F.; Imran, M.; Nawaz, M.A.; Hussain, T.; Ali, M.; Rafiq, M.; Kamil, M.A. Bacterial Biofilm and Associated Infections. J. Chin. Med. Assoc. 2018, 81, 7–11. [Google Scholar] [CrossRef]
- Yap, P.S.X.; Yiap, B.C.; Ping, H.C.; Lim, S.H.E. Essential Oils, A New Horizon in Combating Bacterial Antibiotic Resistance. Open Microbiol. J. 2014, 8, 6–14. [Google Scholar] [CrossRef] [PubMed]
- Becerril, R.; Nerín, C.; Gómez-Lus, R. Evaluation of Bacterial Resistance to Essential Oils and Antibiotics after Exposure to Oregano and Cinnamon Essential Oils. Foodborne Pathog. Dis. 2012, 9, 699–705. [Google Scholar] [CrossRef] [PubMed]
- Chaves, T.P.; Pinheiro, R.E.E.; Melo, E.S.; Soares, M.J.D.S.; Souza, J.S.N.; de Andrade, T.B.; de Lemos, T.L.G.; Coutinho, H.D.M. Essential oil of Eucalyptus Camaldulensis Dehn Potentiates β-Lactam Activity against Staphylococcus Aureus and Escherichia coli Resistant Strains. Ind. Crops Prod. 2018, 112, 70–74. [Google Scholar] [CrossRef]
- Ghellai, L.; Hassaine, H.; Khelil, N.K.; Nas, F.; Aissaoui, N.; Hoceini, A.; Ziouane, S.; Zing, W. Antibacterial Efficacy of Essential Oils of Three Aromatic Plants in Combination with Povidone-Iodine against Staphylococcus Aureus Grown in Biofilm Cultures. J. Appl. Pharm. Sci. 2014, 4, 88–93. [Google Scholar] [CrossRef]
- Builders, P.F. Herbal Medicine. In Herbal Medicine; Builders, P.F., Ed.; IntechOpen: London, UK, 2019; pp. 122–138. [Google Scholar] [CrossRef]
- Pérez-Recalde, M.; Ruiz Arias, I.E.; Hermida, É.B. Could Essential Oils Enhance Biopolymers Performance for Wound Healing? A Systematic Review. Phytomedicine 2018, 38, 57–65. [Google Scholar] [CrossRef]
- Dursun, N.; Liman, N.; Özyazgan, I.; Güneş, I.; Saraymen, R. Role of Thymus Oil in Burn Wound Healing. J. Burn Care Rehabil. 2003, 24, 395–399. [Google Scholar] [CrossRef]
- Lawal, T.O.; Soni, K.K.; Adeniyi, B.A.; Doyle, B.J.; Mahady, G.B. Botanicals for Adjunct Therapy and the Treatment of Multidrug-Resistant Staphylococcal Infections. Fight. Multidrug Resist. Herb. Extr. Essent. Oils Compon. 2013, 135–147. [Google Scholar] [CrossRef]
- Hriouech, S.; Akhmouch, A.A.; Mzabi, A.; Chefchaou, H.; Tanghort, M.; Oumokhtar, B.; Chami, N.; Remmal, A. The Antistaphylococcal Activity of Amoxicillin/Clavulanic Acid, Gentamicin, and 1,8-Cineole Alone or in Combination and Their Efficacy through a Rabbit Model of Methicillin-Resistant Staphylococcus Aureus Osteomyelitis. Evid.-Based Complementary Altern. Med. 2020, 2020, 4271017. [Google Scholar] [CrossRef]
- Chircov, C.; Miclea, I.I.; Grumezescu, V.; Grumezescu, A.M. Essential Oils for Bone Repair and Regeneration—Mechanisms and Applications. Materials 2021, 14, 1867. [Google Scholar] [CrossRef]
- Baptista-Silva, S.; Borges, S.; Ramos, O.L.; Pintado, M.; Sarmento, B. The Progress of Essential Oils as Potential Therapeutic Agents: A Review. J. Essent. Oil Res. 2020, 32, 279–295. [Google Scholar] [CrossRef]
- Reichling, J.; Schnitzler, P.; Suschke, U.; Saller, R. Essential Oils of Aromatic Plants with Antibacterial, Antifungal, Antiviral, and Cytotoxic Properties—An Overview. Forsch. Komplement. 2009, 16, 79–90. [Google Scholar] [CrossRef] [PubMed]
- Adorjan, B.; Buchbauer, G. Biological Properties of Essential Oils: An Updated Review. Flavour Fragr. J. 2010, 25, 407–426. [Google Scholar] [CrossRef]
- Pereira dos Santos, E.; Nicácio, P.H.M.; Coêlho Barbosa, F.; Nunes da Silva, H.; Andrade, A.L.S.; Lia Fook, M.V.; Farias Leite, I. Chitosan/Essential Oils Formulations for Potential Use as Wound Dressing: Physical And. Materials 2019, 12, 2223. [Google Scholar] [CrossRef]
- Chouhan, S.; Sharma, K.; Guleria , S. Antimicrobial Activity of Some Essential Oils—Present Status and Future Perspectives. Medicines 2017, 4, 58. [Google Scholar] [CrossRef]
- Wińska, K.; Mączka, W.; Łyczko, J.; Grabarczyk, M.; Czubaszek, A.; Szumny, A. Essential Oils as Antimicrobial Agents—Myth or Real Alternative? Molecules 2019, 24, 2130. [Google Scholar] [CrossRef]
- Sakkas, H.; Papadopoulou, C. Antimicrobial Activity of Basil, Oregano, and Thyme Essential oils. J. Microbiol. Biotechnol. 2017, 27, 429–438. [Google Scholar] [CrossRef]
- Nuță, D.C.; Limban, C.; Chiriță, C.; Chifiriuc, M.C.; Costea, T.; Ioniță, P.; Nicolau, I.; Zarafu, I. Contribution of Essential Oils to the Fight against Microbial Biofilms—A Review. Processes 2021, 9, 537. [Google Scholar] [CrossRef]
- Bakkali, F.; Averbeck, S.; Averbeck, D.; Idaomar, M. Biological Effects of Essential Oils—A Review. Food Chem. Toxicol. 2008, 46, 446–475. [Google Scholar] [CrossRef]
- Langeveld, W.T.; Veldhuizen, E.J.A.; Burt, S.A. Synergy between Essential Oil Components and Antibiotics: A Review. Crit. Rev. Microbiol. 2014, 40, 76–94. [Google Scholar] [CrossRef] [PubMed]
- Dhifi, W.; Bellili, S.; Jazi, S.; Bahloul, N.; Mnif, W. Essential Oils’ Chemical Characterization and Investigation of Some Biological Activities: A Critical Review. Medicines 2016, 3, 25. [Google Scholar] [CrossRef]
- Inouye, S.; Takizawa, T.; Yamaguchi, H. Antibacterial Activity of Essential Oils and Their Major Constituents against Respiratory Tract Pathogens by Gaseous Contact. J. Antimicrob. Chemother. 2001, 47, 565–573. [Google Scholar] [CrossRef] [PubMed]
- Fisher, K.; Phillips, C. Potential Antimicrobial Uses of Essential Oils in Food: Is Citrus the Answer? Trends Food Sci. Technol. 2008, 19, 156–164. [Google Scholar] [CrossRef]
- Tullio, V.; Nostro, A.; Mandras, N.; Dugo, P.; Banche, G.; Cannatelli, M.A.; Cuffini, A.M.; Alonzo, V.; Carlone, N.A. Antifungal Activity of Essential Oils against Filamentous Fungi Determined by Broth Microdilution and Vapour Contact Methods. J. Appl. Microbiol. 2007, 102, 1544–1550. [Google Scholar] [CrossRef]
- Goñi, P.; López, P.; Sánchez, C.; Gómez-Lus, R.; Becerril, R.; Nerín, C. Antimicrobial Activity in the Vapour Phase of a Combination of Cinnamon and Clove Essential Oils. Food Chem. 2009, 116, 982–989. [Google Scholar] [CrossRef]
- Nadjib, B.M.; Amine, F.M.; Abdelkrim, K.; Fairouz, S.; Maamar, M. Liquid and Vapour Phase Antibacterial Activity of Eucalyptus Globulus Essential Oil = Susceptibility of Selected Respiratory Tract Pathogens. Am. J. Infect. Dis. 2014, 10, 105–117. [Google Scholar] [CrossRef]
- Chao, S.; Young, G.; Oberg, C.; Nakaoka, K. Inhibition of Methicillin-Resistant Staphylococcus Aureus (MRSA) by Essential Oils. Flavour Fragr. J. 2008, 23, 444–449. [Google Scholar] [CrossRef]
- Patterson, J.E.; McElmeel, L.; Wiederhold, N.P. In Vitro Activity of Essential Oils against Gram-Positive and Gram-Negative Clinical Isolates, Including Carbapenem-Resistant Enterobacteriaceae. Open Forum Infect. Dis. 2019, 6, 1–4. [Google Scholar] [CrossRef]
- Vasile, C.; Sivertsvik, M.; Miteluţ, A.C.; Brebu, M.A.; Stoleru, E.; Rosnes, J.T.; Tănase, E.E.; Khan, W.; Pamfil, D.; Cornea, C.P.; et al. Comparative Analysis of the Composition and Active Property Evaluation of Certain Essential Oils to Assess Their Potential Applications in Active Food Packaging. Materials 2017, 10, 45. [Google Scholar] [CrossRef]
- Soković, M.; Glamočlija, J.; Marin, P.D.; Brkić, D.; van Griensven, L.J.L.D. Antibacterial Effects of the Essential Oils of Commonly Consumed Medicinal Herbs Using an in Vitro Model. Molecules 2010, 15, 7532–7546. [Google Scholar] [CrossRef]
- Uzair, B.; Niaz, N.; Bano, A.; Khan, B.A.; Zafar, N.; Iqbal, M.; Tahira, R.; Fasim, F. Essential Oils Showing in Vitro Anti MRSA and Synergistic Activity with Penicillin Group of Antibiotics. Pak. J. Pharm. Sci. 2017, 30, 1997–2002. [Google Scholar]
- Tohidpour, A.; Sattari, M.; Omidbaigi, R.; Yadegar, A.; Nazemi, J. Antibacterial Effect of Essential Oils from Two Medicinal Plants against Methicillin-Resistant Staphylococcus Aureus (MRSA). Phytomedicine 2010, 17, 142–145. [Google Scholar] [CrossRef]
- Kryvtsova, M.V.; Salamon, I.; Koscova, J.; Bucko, D.; Spivak, M. Antimicrobial, Antibiofilm and Biochemichal Properties of Thymus Vulgaris Essential Oil against Clinical Isolates of Opportunistic Infections. Biosyst. Divers. 2019, 27, 270–275. [Google Scholar] [CrossRef]
- Mardafkan, N.; Iranmanesha, M.; Larijani, K.; Mahasti, P.; Nazari, F.; Zojaji, M. Chemical Components and Antibacterial Activities of Essential Oils Obtained From Iranian Local Lavandula Officinalis and Thymus Vulgaris Against Pathogenic Bacteria Isolated From Human. J. Food Biosci. Technol. 2015, 5, 31–36. [Google Scholar]
- Lemos, M.F.; Lemos, M.F.; Pacheco, H.P.; Guimarães, A.C.; Fronza, M.; Endringer, D.C.; Scherer, R. Seasonal Variation Affects the Composition and Antibacterial and Antioxidant Activities of Thymus Vulgaris. Ind. Crops Prod. 2017, 95, 543–548. [Google Scholar] [CrossRef]
- Voravuthikunchai, S.P.; Minbutra, S.; Goodla, L.; Jefferies, J.; Voravuthikunchai, S. Mixtures of Essential Oils in an Air Conditioning Prototype to Reduce the Prevalence of Airborne Pathogenic Bacteria. J. Essent. Oil-Bear. Plants 2012, 15, 739–749. [Google Scholar] [CrossRef]
- Ács, K.; Bencsik, T.; Böszörményi, A.; Kocsis, B.; Horváth, G. Essential Oils and Their Vapors as Potential Antibacterial Agents against Respiratory Tract Pathogens. Nat. Prod. Commun. 2016, 11, 1709–1712. [Google Scholar] [CrossRef]
- Frankova, A.; Kloucek, P.S.J.; Nedorostova, L. Testing the Antimicrobial Activity of Essential Oils. Acta Agrar. Debr. 2011, 44, 71–74. [Google Scholar] [CrossRef]
- Nedorostova, L.; Kloucek, P.; Urbanova, K.; Kokoska, L.; Smid, J.; Urban, J.; Valterova, I.; Stolcova, M. Antibacterial Effect of Essential Oil Vapours against Different Strains of Staphylococcus Aureus, Including MRSA. Flavour Fragr. J. 2011, 26, 403–407. [Google Scholar] [CrossRef]
- Dobre, A.A.; Gagiu, V.; Petru, N. Antimicrobial Activity of Essential Oils against Food-Borne Bacteria Evaluated by Two Preliminary Methods. Rom. Biotechnol. Lett. 2011, 16, 119–125. [Google Scholar]
- Ghabraie, M.; Vu, K.D.; Tata, L.; Salmieri, S.; Lacroix, M. Antimicrobial Effect of Essential Oils in Combinations against Five Bacteria and Their Effect on Sensorial Quality of Ground Meat. LWT Food Sci. Technol. 2016, 66, 332–339. [Google Scholar] [CrossRef]
- López, P.; Sánchez, C.; Batlle, R.; Nerín, C. Vapor-Phase Activities of Cinnamon, Thyme, and Oregano Essential Oils and Key Constituents against Foodborne Microorganisms. J. Agric. Food Chem. 2007, 55, 4348–4356. [Google Scholar] [CrossRef]
- Nedorostova, L.; Kloucek, P.; Kokoska, L.; Stolcova, M.; Pulkrabek, J. Antimicrobial Properties of Selected Essential Oils in Vapour Phase against Foodborne Bacteria. Food Control 2009, 20, 157–160. [Google Scholar] [CrossRef]
- Lisin, G.; Safiyev, S.; Craker, L.E. Antimicrobial Activity of Some Essential Oils. Acta Hortic. 1999, 501, 283–287. [Google Scholar] [CrossRef]
- Andrade, B.F.M.T.; Barbosa, L.N.; Alves, F.C.B.; Albano, M.; Rall, V.L.M.; Sforcin, J.M.; Fernandes, A.A.H.; Fernandes, A. The Antibacterial Effects of Melaleuca Alternifolia, Pelargonium Graveolens and Cymbopogon Martinii Essential Oils and Major Compounds on Liquid and Vapor Phase. J. Essent. Oil Res. 2016, 28, 227–233. [Google Scholar] [CrossRef]
- Brożyna, M.; Żywicka, A.; Fijałkowski, K.; Gorczyca, D.; Oleksy-Wawrzyniak, M.; Dydak, K.; Migdał, P.; Dudek, B.; Bartoszewicz, M.; Junka, A. The Novel Quantitative Assay for Measuring the Antibiofilm Activity of Volatile Compounds (Antibiovol). Appl. Sci. 2020, 10, 7343. [Google Scholar] [CrossRef]
- Abers, M.; Schroeder, S.; Goelz, L.; Sulser, A.; st. Rose, T.; Puchalski, K.; Langland, J. Antimicrobial Activity of the Volatile Substances from Essential Oils. BMC Complementary Med. Ther. 2021, 21, 124. [Google Scholar] [CrossRef]
- Martin, M.J.; Trujillo, L.A.; Garcia, M.C.; Alfaro, M.C.; Muñoz, J. Effect of Emulsifier HLB and Stabilizer Addition on the Physical Stability of Thyme Essential Oil Emulsions. J. Dispers. Sci. Technol. 2018, 39, 1627–1634. [Google Scholar] [CrossRef]
- Dudek-Wicher, R.; Paleczny, J.; Kowalska-Krochmal, B.; Szymczyk-Ziółkowska, P.; Pachura, N.; Szumny, A.; Brożyna, M. Activity of Liquid and Volatile Fractions of Essential Oils against Biofilm Formed by Selected Reference Strains on Polystyrene and Hydroxyapatite Surfaces. Pathogens 2021, 10, 515. [Google Scholar] [CrossRef]
- Murbach Teles Andrade, B.F.; Nunes Barbosa, L.; da Silva Probst, I.; Fernandes Júnior, A. Antimicrobial Activity of Essential Oils. J. Essent. Oil Res. 2014, 26, 34–40. [Google Scholar] [CrossRef]
- Sakkas, H.; Economou, V.; Gousia, P.; Bozidis, P.; Sakkas, V.A.; Petsios, S.; Mpekoulis, G.; Ilia, A.; Papadopoulou, C. Antibacterial Efficacy of Commercially Available Essential Oils Tested against Drug-Resistant Gram-Positive Pathogens. Appl. Sci. 2018, 10, 2201. [Google Scholar] [CrossRef]
- Hussain, A.I.; Anwar, F.; Nigam, P.S.; Ashraf, M.; Gilani, A.H. Seasonal Variation in Content, Chemical Composition and Antimicrobial and Cytotoxic Activities of Essential Oils from Four Mentha Species. J. Sci. Food Agric. 2010, 90, 1827–1836. [Google Scholar] [CrossRef]
- Sadekuzzaman, M.; Mizan, M.F.R.; Kim, H.S.; Yang, S.; Ha, S.-D. Activity of Thyme and Tea Tree Essential Oils against Selected Foodborne Pathogens in Biofilms on Abiotic Surfaces. LWT Food Sci. Technol. 2018, 89, 134–139. [Google Scholar] [CrossRef]
- Horváth, P.; Koščová, J. In Vitro Antibacterial Activity of Mentha Essential Oils against Staphylococcus Aureus. Folia Vet. I 2017, 61, 71–77. [Google Scholar] [CrossRef][Green Version]
- Li, J.; Chang, J.W.; Saenger, M.; Deering, A. Thymol Nanoemulsions Formed via Spontaneous Emulsification: Physical and Antimicrobial Properties. Food Chem. 2017, 232, 191–197. [Google Scholar] [CrossRef] [PubMed]
- Kachur, K.; Suntres, Z. The Antibacterial Properties of Phenolic Isomers, Carvacrol and Thymol. Crit. Rev. Food Sci. Nutr. 2020, 60, 3042–3053. [Google Scholar] [CrossRef] [PubMed]
- Gömöri, C.; Vidács, A.; Kerekes, E.B.; Nacsa-Farkas, E.; Böszörményi, A.; Vágvölgyi, C.; Krisch, J. Altered Antimicrobial and Anti-Biofilm Forming Effect of Thyme Essential Oil Due to Changes in Composition. Nat. Prod. Commun. 2018, 13, 483–487. [Google Scholar] [CrossRef]
- Feng, C.H.; Yu, L.; Zhen, Y.; Yanan, M.O.; Ruofeng, S.; Baocheng, H.; Xuehong, W.; Jianping, L. Effect of Tea Tree Oil on Methicillin-Resistant Staphylococcus Aureus Biofilm. Sci. Technol. Food Ind. 2021, 42, 107–112. [Google Scholar] [CrossRef]
- Endo, E.H.; Costa, G.M.; Makimori, R.Y.; Ueda-Nakamura, T.; Nakamura, C.V.; Dias Filho, B.P. Anti-Biofilm Activity of Rosmarinus Officinalis, Punica Granatum and Tetradenia Riparia against Methicillin-Resistant Staphylococcus Aureus (MRSA) and Synergic Interaction with Penicillin. J. Herb. Med. 2018, 14, 48–54. [Google Scholar] [CrossRef]
- Nazir, U.; Javaid, S.; Awais, H.; Bashir, F.; Shahid, M. Biochemical Potential and Screening of Bioactive Components of Ocimum Basilicum. Pure Appl. Biol. 2021, 10, 1004–1013. [Google Scholar] [CrossRef]
- Ivopol, M.; Vlăsceanu, G.; Dune, A.; Popa, M.; Măruţescu, L.; Ionescu, D.; Ivopol, G.-C.; Crişan, I.; Chifiriuc, C. In Vitro Investigation of Some Plant Essential Oils for Potential Antimicrobial Activity. In The National Congress of Pharmacy, 17th ed.; Filodiritto Editore: Bucharest, Romania, 2018; p. 9. [Google Scholar]
- Kifer, D.; Mužinić, V.; Klaric, M.Š. Antimicrobial Potency of Single and Combined Mupirocin and Monoterpenes, Thymol, Menthol and 1,8-Cineole against Staphylococcus Aureus Planktonic and Biofilm Growth. J. Antibiot. 2016, 69, 689–696. [Google Scholar] [CrossRef] [PubMed]
- Merghni, A.; Noumi, E.; Hadded, O.; Dridi, N.; Panwar, H.; Ceylan, O.; Mastouri, M.; Snoussi, M. Assessment of the Antibiofilm and Antiquorum Sensing Activities of Eucalyptus Globulus Essential Oil and Its Main Component 1,8-Cineole against Methicillin-Resistant Staphylococcus Aureus Strains. Microb. Pathog. 2018, 118, 74–80. [Google Scholar] [CrossRef]
- Kavanaugh, N.L.; Ribbeck, K. Selected Antimicrobial Essential Oils Eradicate Pseudomonas Spp. And Staphylococcus Aureus Biofilms. Appl. Environ. Microbiol. 2012, 78, 4057–4061. [Google Scholar] [CrossRef]
- Blažeković, B.; Yang, W.; Wang, Y.; Li, C.; Kindl, M.; Pepeljnjak, S.; Vladimir-Knežević, S. Chemical Composition, Antimicrobial and Antioxidant Activities of Essential Oils of Lavandula × intermedia ‘Budrovka’ and L. Angustifolia Cultivated in Croatia. Ind. Crops Prod. 2018, 123, 173–182. [Google Scholar] [CrossRef]
- Kot, B.; Wierzchowska, K.; Grużewska, A.; Lohinau, D. The Effects of Selected Phytochemicals on Biofilm Formed by Five Methicillin-Resistant Staphylococcus Aureus. Nat. Prod. Res. 2018, 32, 1299–1302. [Google Scholar] [CrossRef]
- Junka, A.; Żywicka, A.; Chodaczek, G.; Dziadas, M.; Czajkowska, J.; Duda-Madej, A.; Bartoszewicz, M.; Mikołajewicz, K.; Krasowski, G.; Szymczyk, P.; et al. Potential of Biocellulose Carrier Impregnated with Essential Oils to Fight Against Biofilms Formed on Hydroxyapatite. Sci. Rep. 2019, 9, 1–13. [Google Scholar] [CrossRef]
- Valliammai, A.; Selvaraj, A.; Yuvashree, U.; Aravindraja, C.; Karutha Pandian, S. SarA-Dependent Antibiofilm Activity of Thymol Enhances the Antibacterial Efficacy of Rifampicin Against Staphylococcus Aureus. Front. Microbiol. 2020, 11, 1–13. [Google Scholar] [CrossRef]
- Trombetta, D.; Castelli, F.; Sarpietro, M.G.; Venuti, V.; Cristani, M.; Daniele, C.; Saija, A.; Mazzanti, G.; Bisignano, G. Mechanisms of antibacterial action of three monoterpenes. Antimicrob. Agents Chemother. 2005, 49, 2474–2478. [Google Scholar] [CrossRef]
- Bajalan, I.; Rouzbahani, R.; Ghasemi Pirbalouti, A.; Maggi, F. Antioxidant and antibacterial activities of the essential oils obtained from seven Iranian populations of Rosmarinus officinalis. Ind. Crops Prod. 2017, 305–311. [Google Scholar] [CrossRef]
- Li, L.; Li, Z.W.; Yin, Z.Q.; Wei, Q.; Jia, R.Y.; Zhou, L.J.; Xu, J.; Song, X.; Zhou, Y.; Du, Y.H.; et al. Antibacterial activity of leaf essential oils and its constituents from Cinnamomum longe paniculatum. Int. J. Clin. Exp. Med. 2014, 7, 1721–1727. [Google Scholar] [PubMed]
- Maillard, J.Y.; Kampf, G.; Cooper, R. Antimicrobial stewardship of antiseptics that are pertinent to wounds: The need for a united approach. JAC Antimicrob. Resist. 2021, 3, dlab027. [Google Scholar] [CrossRef]
- Mutlu-Ingok, A.; Firtin, B.; Karbancioglu-Guler, F.; Altay, F. A study on correlations between antimicrobial effects and diffusion coefficient, zeta potential and droplet size of essential oils. Int. J. Food Eng. 2020, 16, 20190354. [Google Scholar] [CrossRef]
- Junka, A.F.; Żywicka, A.; Szymczyk, P.; Dziadas, M.; Bartoszewicz, M.; Fijałkowski, K.A.D.A.M. Test (Antibiofilm Dressing’s Activity Measurement)—Simple Method for Evaluating Anti-Biofilm Activity of Drug-Saturated Dressings against Wound Pathogens. J. Microbiol. Methods 2017, 143, 6–12. [Google Scholar] [CrossRef] [PubMed]

| Zones of Growth Inhibition (mm) after Treatment with Liquid Fractions of EOs | |||||||
|---|---|---|---|---|---|---|---|
| Strain | T-EO | TT-EO | B-EO | R-EO | E-EO | M-EO | L-EO |
| 2 | 56 (±9.29) | 8 (±6.66) | 8 (±1.15) | 41 (±0.58) | 0 (±0.00)/4.5 | 15 (±2.65) | 9 (±1.00) |
| 4 | 57(±16.50) | 9 (±1.15)/3.3 | 9 (±1.00) | 32 (±1.53) | 0 (±0.00)/4.8 | 14 (±2.31) | 8 (±1.15) |
| 5 | 36 (±4.04) | 15 (±2.89) | 10 (±1.00) | 40 (±3.46) | 8 (±0.58) | 12 (±2.31) | 9 (±1.00) |
| 6 | 35 (±3.06) | 15 (±1.73) | 8 (±0.58) | 32 (±0.58) | 8 (±1.15) | 11 (±1.53) | 12 (±2.65) |
| 7 | 55 (±13.87) | 20 (±10.79)/2.0 | 17 (±0.58) | 45 (±0.00) | 0 (±0.00)/6.7 | 13 (±1.73) | 9 (±1.15) |
| 10 | 61 (±2.31) | 14 (±1.15) | 9 (±2.31) | 35 (±0.58) | 0 (±0.00)/4.7 | 12 (±1.53) | 9 (±0.58) |
| 26 | 43 (±3.79) | 14 (±3.21) | 14 (±2.08) | 42 (±0.58) | 0 (±0.00)/5.7 | 15 (±0.58) | 9 (±1.00) |
| 27 | 60 (±13.86)/7.0 | 17 (±3.06) | 9 (±0.58) | 27 (±3.06) | 8 (±0.58)/2.0 | 13 (±2.00) | 10 (±1.15) |
| 28 | 39 (±6.56)/4.2 | 19 (±4.04) | 12 (±5.29) | 33 (±1.53) | 10 (±2.08)/2.5 | 15 (±1.15) | 12 (±2.00) |
| 29 | 51 (±5.13) | 13 (±1.15) | 9 (±1.53) | 38 (±3.21) | 3 (±5.20)/6.0 | 10 (±0.00) | 9 (±2.65) |
| 32 | 50 (±9.87) | 18 (±1.53) | 13 (±1.15) | 35 (±0.00) | 11 (±0.58) | 14 (±0.58) | 10 (±0.58) |
| 33 | 56 (±1.73)/17.0 | 24 (±1.53) | 18 (±0.00) | 51 (±1.00) | 0 (±0.00)/5.5 | 19 (±6.56)/6.5 | 14 (±2.89)/37.0 |
| 34 | 40 (±6.35) | 10 (±1.00) | 18 (±0.58) | 34 (±0.58) | 11 (±1.15) | 10 (±0.58) | 8 (±1.00) |
| 35 | 39 (±5.69) | 13 (±1.53) | 18 (±0.58) | 43 (±1.73) | 8 (±0.58)/2.3 | 14 (±3.61) | 9 (±0.58) |
| ATCC 33591 | 43 (±3.06) | 17 (±3.51) | 9 (±0.00) | 37 (±0.00) | 3 (±4.62)/4.0 | 17 (±10.44) | 10 (±1.00) |
| ATCC 6538 | 77(±12.58) | 30(±5.00) | 12 (±0.58) | 14 (±5.13) | 30(±0.5.8) | 14 (±3.21) | 10 (±0.58) |
| Zones of Growth Inhibition (mm) after Treatment with Volatile Fractions of EOs | |||||||
|---|---|---|---|---|---|---|---|
| Strain | T-EO | TT-EO | B-EO | R-EO | E-EO | M-EO | L-EO |
| 2 | 30 (±4.93) | 0 (±0.00) | 0 (±0.00) | 13 (±8.66) | 0 (±0.00) | 11 (±1.73) | 0 (±0.00) |
| 4 | 32 (±1.00) | 0 (±0.00) | 0 (±0.00) | 0 (±0.00)/10.5 | 0 (±0.00)/9.3 | 7 (±1.15) | 0 (±0.00) |
| 5 | 24 (±1.15) | 0 (±0.00) | 0 (±0.00) | 0 (±0.00)/11.5 | 8 (±6.93)/9.2 | 2 (±3.46) | 0 (±0.00) |
| 6 | 24 (±1.15) | 0 (±0.00) | 0 (±0.00) | 0 (±0.00)/11.2 | 0 (±0.00)/12.3 | 0 (±0.00) | 0 (±0.00) |
| 7 | 31 (±0.00) | 0 (±0.00) | 0 (±0.00) | 0 (±0.00)/13.0 | 6 (±9.81)/7.0 | 2 (±4.04) | 0 (±0.00) |
| 10 | 31 (±1.15) | 0 (±0.00) | 0 (±0.00) | 29 (±2.65) | 27 (±1.73) | 11 (±0.00) | 0 (±0.00) |
| 26 | 28 (±2.08) | 0 (±0.00) | 0 (±0.00) | 0 (±0.00)/13.5 | 15 (±13.61)/12.5 | 2 (±4.04) | 0 (±0.00) |
| 27 | 30 (±3.06) | 0 (±0.00) | 0 (±0.00) | 0 (±0.00) | 0 (±0.00)/7.5 | 9 (±2.00) | 0 (±0.00) |
| 28 | 29 (±4.51) | 0 (±0.00) | 0 (±0.00) | 29 (±2.52) | 26 (±0.58) | 8 (±7.00) | 0 (±0.00) |
| 29 | 31 (±2.08) | 0 (±0.00) | 0 (±0.00) | 0 (±0.00)/14.2 | 7 (±11.55)/10.5 | 0 (±0.00)/3.8 | 0 (±0.00) |
| 32 | 27 (±1.00) | 0 (±0.00) | 0 (±0.00) | 9 (±15.59)/21.5 | 0 (±0.00)/12.7 | 0 (±0.00)/5.2 | 0 (±0.00) |
| 33 | 30 (±1.73)/13.2 | 0 (±0.00)/7.5 | 0 (±0.00)/13.0 | 28 (±1.15)/1.5 | 0 (±0.00)/13.8 | 0 (±0.00)/13.8 | 0 (±0.00)/22.8 |
| 34 | 25 (±2.65) | 0 (±0.00) | 0 (±0.00) | 20 (±1.15)/2.8 | 18 (±1.73) | 0 (±0.00) | 0 (±0.00) |
| 35 | 21 (±1.15) | 14 (±12.77) | 0 (±0.00) | 0 (±0.00)/13.5 | 0 (±0.00)/6 | 0 (±0.00) | 0 (±0.00) |
| ATCC 33591 | 37 (±0.58)/3.7 | 0 (±0.00)/5.5 | 0 (±0.00) | 4 (±6.35)/10.0 | 0 (±0.00)/6.2 | 12 (±4.93) | 0 (±0.00) |
| ATCC 6538 | 43 (±5.03) | 15 (±6.81) | 0 (±0.00) | 49 (±5.29) | 0 (±0.00) | 18 (±2.65) | 0 (±0.00) |
| T-EO | TT-EO | B-EO | R-EO | E-EO | M-EO | L-EO | ||||||||
|---|---|---|---|---|---|---|---|---|---|---|---|---|---|---|
| Strain | MIC (%) | MBEC (%) | MIC (%) | MBEC (%) | MIC (%) | MBEC (%) | MIC (%) | MBEC (%) | MIC (%) | MBEC (%) | MIC (%) | MBEC (%) | MIC (%) | MBEC (%) |
| 2 | 0.05 | 0.05 | 0.1 | 1.6 | 1.6 | 25 | 0.4 | 12.5 | 1.6 | - | 0.05 | 50 | 0.2 | - |
| 4 | 0.05 | 0.05 | 0.2 | 1.6 | 1.6 | 50 | 0.4 | 6.3 | 0.8 | - | 0.05 | 0.2 | 0.8 | - |
| 5 | 0.05 | 0.05 | 0.8 | 1.6 | 1.6 | 12.5 | 0.8 | 6.3 | 0.8 | - | 0.4 | 50 | 0.8 | - |
| 6 | 0.1 | 0.1 | 0.4 | 1.6 | 3.1 | - | 0.8 | 3.1 | 1.6 | - | 0.2 | - | 3.1 | - |
| 7 | 0.05 | 0.05 | 0.4 | 3.1 | 3.1 | - | 0.8 | 50 | 1.6 | - | 0.1 | - | 1.6 | - |
| 10 | 0.05 | 0.05 | 0.2 | 3.1 | 0.8 | - | 0.4 | 50 | 1.6 | - | 0.1 | - | 0.4 | - |
| 26 | 0.05 | 0.05 | 0.2 | 6.3 | 0.8 | 12.5 | 0.4 | 6.3 | 0.8 | - | 0.1 | 3.1 | 0.8 | - |
| 27 | 0.025 | 0.05 | 0.8 | 6.3 | 1.6 | - | 0.1 | 25 | 6.3 | - | 0.2 | 50 | 1.6 | - |
| 28 | 0.05 | 0.1 | 0.2 | 3.1 | 0.8 | 25 | 0.4 | 6.3 | 1.6 | - | 0.1 | 0.2 | 0.4 | - |
| 29 | 0.05 | 0.1 | 0.8 | 1.6 | 3.1 | 50 | 0.8 | - | 1.6 | - | 0.1 | 0.4 | 1.6 | - |
| 32 | 0.05 | 0.1 | 0.2 | 6.3 | 0.8 | 12.5 | 0.4 | 6.3 | 0.8 | - | 0.2 | - | 0.8 | - |
| 33 | 0.05 | 0.1 | 0.1 | 6.3 | 1.6 | - | 0.4 | 50 | 0.1 | - | 0.05 | - | 0.2 | - |
| 34 | 0.05 | 0.1 | 0.4 | 6.3 | 0.4 | 25 | 0.4 | - | 3.1 | - | 0.2 | 50 | 0.2 | - |
| 35 | 0.05 | 0.1 | 0.2 | 1.6 | 1.6 | 25 | 0.4 | 50 | 1.6 | - | 0.2 | 50 | 0.8 | - |
| ATCC 33591 | 0.1 | 0.1 | 0.2 | 3.1 | 1.6 | 50 | 0.4 | 12.5 | 0.8 | - | 0.1 | 0.8 | 0.4 | - |
| ATCC 6538 | 0.025 | 0.4 | 0.1 | 0.8 | 0.8 | 12.5 | 0.4 | 6.3 | 0.8 | - | 0.1 | 0.2 | 0.2 | 1.6 |
| Wound Infection Strains | Bone Infection Strains | ||
|---|---|---|---|
| MSSA | MRSA | MSSA | MRSA |
| SA 2 | SA 26 | SA 6 | SA 32 |
| SA 4 | SA 27 | SA 7 | SA 33 |
| SA 5 | SA 28 | SA 10 | SA 34 |
| SA 29 | SA 35 | ||
Publisher’s Note: MDPI stays neutral with regard to jurisdictional claims in published maps and institutional affiliations. |
© 2021 by the authors. Licensee MDPI, Basel, Switzerland. This article is an open access article distributed under the terms and conditions of the Creative Commons Attribution (CC BY) license (https://creativecommons.org/licenses/by/4.0/).
Share and Cite
Brożyna, M.; Paleczny, J.; Kozłowska, W.; Chodaczek, G.; Dudek-Wicher, R.; Felińczak, A.; Gołębiewska, J.; Górniak, A.; Junka, A. The Antimicrobial and Antibiofilm In Vitro Activity of Liquid and Vapour Phases of Selected Essential Oils against Staphylococcus aureus. Pathogens 2021, 10, 1207. https://doi.org/10.3390/pathogens10091207
Brożyna M, Paleczny J, Kozłowska W, Chodaczek G, Dudek-Wicher R, Felińczak A, Gołębiewska J, Górniak A, Junka A. The Antimicrobial and Antibiofilm In Vitro Activity of Liquid and Vapour Phases of Selected Essential Oils against Staphylococcus aureus. Pathogens. 2021; 10(9):1207. https://doi.org/10.3390/pathogens10091207
Chicago/Turabian StyleBrożyna, Malwina, Justyna Paleczny, Weronika Kozłowska, Grzegorz Chodaczek, Ruth Dudek-Wicher, Anna Felińczak, Joanna Gołębiewska, Agata Górniak, and Adam Junka. 2021. "The Antimicrobial and Antibiofilm In Vitro Activity of Liquid and Vapour Phases of Selected Essential Oils against Staphylococcus aureus" Pathogens 10, no. 9: 1207. https://doi.org/10.3390/pathogens10091207
APA StyleBrożyna, M., Paleczny, J., Kozłowska, W., Chodaczek, G., Dudek-Wicher, R., Felińczak, A., Gołębiewska, J., Górniak, A., & Junka, A. (2021). The Antimicrobial and Antibiofilm In Vitro Activity of Liquid and Vapour Phases of Selected Essential Oils against Staphylococcus aureus. Pathogens, 10(9), 1207. https://doi.org/10.3390/pathogens10091207








